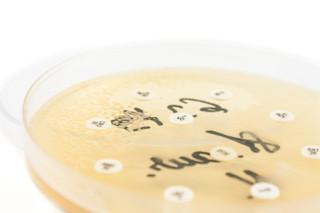

当两种或多种细菌在人体内部相遇时,它们可能会表现出不可预测的行为,放弃对通常的抗生素反应。德克萨斯大学奥斯汀分校的研究人员最近观察到,细菌种类可以“勾结”以使抗生素治疗更加困难。
广告
金黄色葡萄球菌和铜绿假单胞菌通常会共同感染伤口、导管和囊性纤维化患者的肺部。葡萄球菌通常无害,但当它存在于铜绿假单胞菌时……情况可能会变得更加严重。
为了更好地理解细菌之间的微妙关系,该团队需要一种方法来一起研究这两种细菌。生物工程师杰森·希尔将每种细菌的菌落困在冷却(并固化)的蛋白质液体中的独立水坑中。这些蛋白质具有光反应性,响应激光光束而结合在一起。这使得希尔能够用液体描绘出超薄、大部分透明的墙壁,并将它们连接成笼子,从而困住独立的菌落。
希尔将一个葡萄球菌笼子嵌套在一个铜绿假单胞菌笼子内,让两个菌落生活在狭小、受控的环境中。明胶笼子的墙壁允许食物和废物在种群之间来回流动。仅仅被铜绿假单胞菌包围几个小时,葡萄球菌就变得耐抗生素。希尔认为,这是因为铜绿假单胞菌自然产生的特定酶β-内酰胺酶也进入了葡萄球菌笼子。
这项研究可能会促使医院更好地准备预测和应对存在多种菌群时的细菌感染变化。该团队的下一步计划是研究其他细菌化学物质和分子——甚至像氧气这样简单的物质——在与另一个菌群密切接触时如何改变细菌行为。